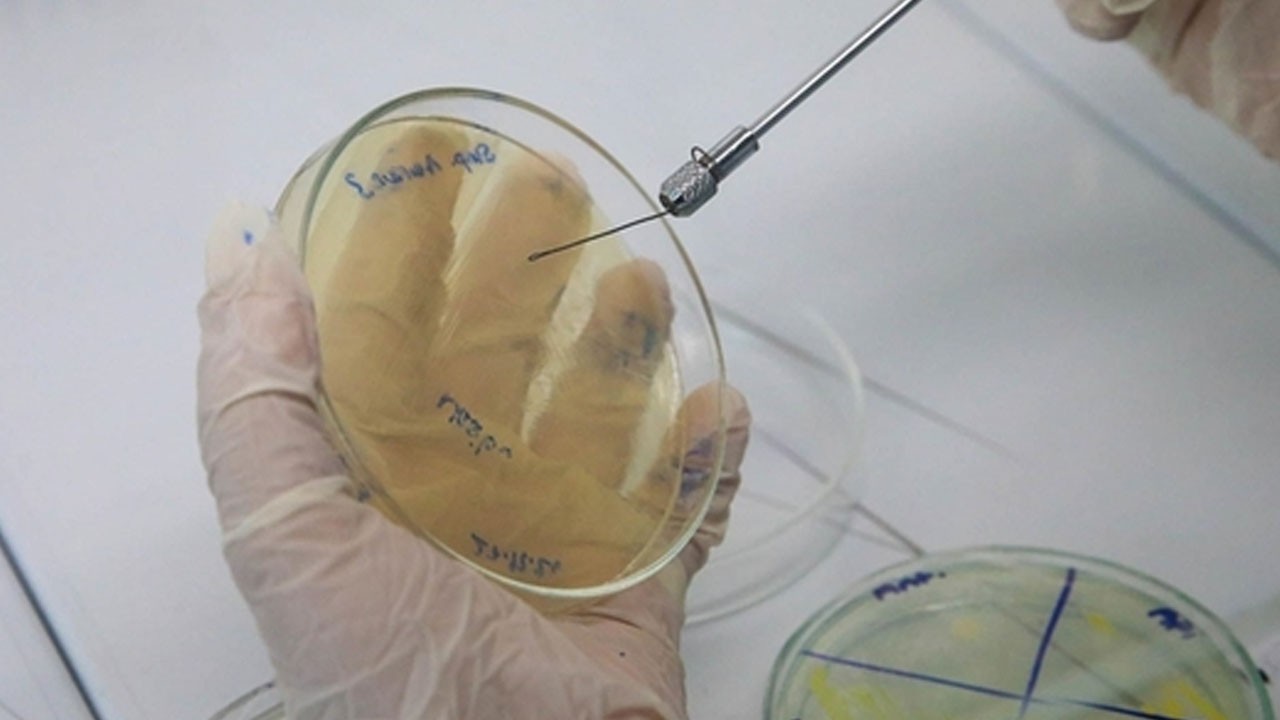
Erkek arı larvasının bakteriler üzerinde antibiyotik etkisi var: O hayvan öne çıktı

Sabiha Gökçen Havalimanı’nda tilki alarmı! Uçuşlar durduruldu
Sabiha Gökçen Havalimanı’nda bir pilotun pist çevresinde tilki gördüğünü bildirmesi üzerine kalkış trafiği kısa süreliğine durduruldu. Havalimanı ekipleri pist çevresinde inceleme yaparak güvenliği sağladı. Kontrollerin tamamlanmasının ardından uçuşlar normale döndü. O anlar, pilot ile hava trafik kontrolü arasındaki telsiz konuşmalarına yansıdı.
SABİHA Gökçen Havalimanı'nda bir pilot'un pist çevresinde gördüğü tilki nedeniyle kalkış trafiği bir süre durduruldu. Pist çevresi ve üstü kontrol edildikten sonra uçuşlar normale dönerken pilot'un tilkiyi görerek hava trafik kontrolörlerini uyardığı anlar telsiz konuşmalarına yansıdı.
Sabiha Gökçen Havalimanı'nda dün akşam saatlerinde meydana gelen olayda bir pilot, pist yakınlarında tilki gördü. Tilkinin piste doğru ilerlediğini fark eden pilot, Sabiha Gökçen Havalimanı Hava Trafik Kontrol Merkezi ile irtibata geçerek durum hakkında bilgi verdi. Bunun üzerine havalimanında kalkış trafiği bir süre durdurulurken apron görevlileri pist üstü ve çevresinde tilki kontrolü yaptı. Pilot'un tilkiyi görerek hava trafik kontrolörlerini uyardığı anlar telsiz konuşmalarına yansıdı. (DHA)